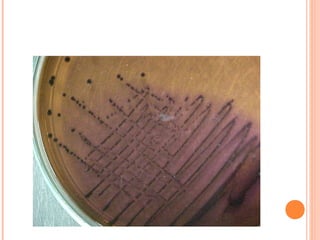

Las bacterias coliformes, incluida la Escherichia coli, se encuentran comúnmente en los excrementos humanos y animales. La presencia de coliformes fecales en el agua indica una posible contaminación con heces, lo que representa un riesgo para la salud. Estos microorganismos se usan como indicadores de contaminación fecal debido a que son fáciles de detectar en el laboratorio y siempre están presentes en las heces.